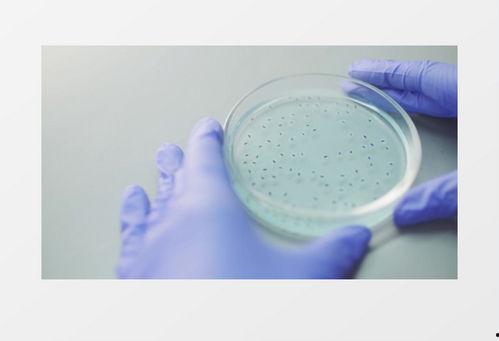

亲爱的读者们,你是否曾在网上看到那些神奇的培养皿实验,心生向往却又不知从何下手?别急,今天我就要来给你揭秘培养皿的正确使用方法,让你也能在家轻松玩转科学实验!
一、培养皿的起源与用途
培养皿,这个看似普通的玻璃器皿,其实有着悠久的历史。早在古希腊时期,人们就开始使用类似培养皿的容器来培养植物。如今,培养皿已经成为实验室中不可或缺的工具,广泛应用于生物学、化学、医学等领域。
那么,培养皿究竟有什么用途呢?简单来说,它主要有以下几个作用:
1. 培养微生物:在微生物学实验中,培养皿是必不可少的。通过在培养皿中接种微生物,我们可以观察它们的生长情况,研究它们的特性。
2. 进行化学反应:在化学实验中,培养皿可以用来进行小规模的化学反应,观察反应过程和结果。
3. 培养植物组织:在植物组织培养中,培养皿是承载植物组织的重要容器,有助于植物组织的生长和分化。
二、培养皿的正确使用方法
了解了培养皿的用途,接下来就是如何正确使用它了。以下是一些关键步骤:
1. 选择合适的培养皿:根据实验需求,选择不同规格、材质的培养皿。常见的有玻璃培养皿、塑料培养皿等。
2. 清洗与消毒:在使用培养皿之前,一定要进行彻底的清洗和消毒。可以使用洗涤剂和清水清洗,然后用酒精或消毒液进行消毒。
3. 接种:在接种微生物或植物组织时,要确保操作环境无菌。可以使用无菌操作台、无菌手套等工具,避免污染。
4. 培养:将接种好的培养皿放置在适宜的温度和湿度环境中进行培养。注意观察培养过程中的变化,及时调整培养条件。
5. 观察与记录:在培养过程中,要定期观察培养皿中的微生物或植物组织,记录它们的生长情况。这有助于我们分析实验结果,得出结论。
三、培养皿的正确使用视频
为了让大家更直观地了解培养皿的正确使用方法,我为大家找到了一些优秀的培养皿使用视频。以下是一些推荐:
1. 《培养皿的正确使用方法》:这是一段时长约5分钟的视频,详细介绍了培养皿的清洗、消毒、接种、培养等步骤。
2. 《微生物培养实验操作教程》:这是一段时长约10分钟的视频,以微生物培养实验为例,展示了培养皿的正确使用方法。
3. 《植物组织培养实验操作教程》:这是一段时长约8分钟的视频,以植物组织培养实验为例,介绍了培养皿的正确使用方法。
四、培养皿使用注意事项
在使用培养皿的过程中,还有一些注意事项需要我们注意:
1. 避免交叉污染:在操作过程中,要确保不同实验之间不发生交叉污染。
2. 保持无菌操作:无菌操作是保证实验结果准确性的关键。
3. 定期更换培养皿:在使用过程中,要定期更换培养皿,避免污染。
4. 妥善处理废弃物:实验结束后,要妥善处理废弃物,避免对环境造成污染。
五、
通过本文的介绍,相信你已经对培养皿的正确使用方法有了更深入的了解。只要掌握了这些技巧,你也能轻松玩转科学实验,开启一段奇妙的探索之旅!快来试试吧,让我们一起感受科学的魅力!
文章声明:以上内容(如有图片或视频在内)除非注明,否则均为亚洲电影大全原创文章,转载或复制请以超链接形式并注明出处。
本文作者:admin本文链接:https://yzsp91zxjx.com/post/701.html